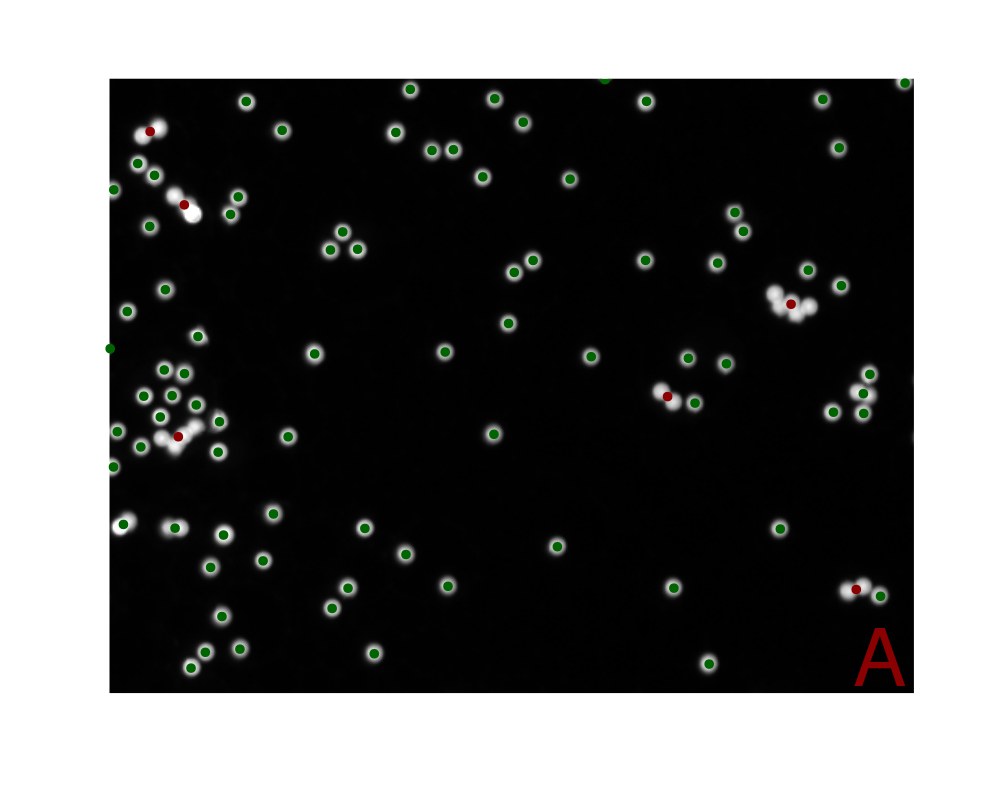
Clustering Microbeads Based on Shape and Intensity Features: A) The utilization of Self-Organizing Maps (SOM) enables the clustering of microbeads into two distinct groups based on shape and intensity features extracted using the shapeFeatures() function. This method enables the precise clustering of microbeads according to a range of properties, including intensity, area, perimeter, circularity, radius, and aspect ratio. This facilitates a deeper understanding of the morphological variations observed in the microbeads. B) The attributes utilized as input for the SOM algorithm are illustrated in this plot. To ensure comparability, the different parameters have been normalized using a min-max normalization procedure. The points highlighted in red represent the microbeads that are also highlighted in red in Figure A. Notably, these highlighted points differ from the most commonly occurring values in all attributes except for the intensity.

This review offers an overview of image processing packages in R, covering applications such as multiplex imaging, cell tracking, and general-purpose tools. We found 38 R packages for image analysis, with adimpro and EBImage being the oldest, published in 2006, and biopixR among the newest, released in 2024. Of these packages, over 90 % are still active, with two-thirds receiving updates within the last 1.5 years. The pivotal role of bioimage informatics in life sciences is emphasized in this review, along with the ongoing advancements of R’s functionality through novel code releases. It focuses on complete analysis pipelines for extracting valuable information from biological images and includes real-world examples. Demonstrating how researchers can use R to tackle new scientific challenges in image analysis, the review provides a comprehensive understanding of R’s utility in this field.
Advancements in microscopy and computational tools have become pivotal to biological research, facilitating detailed investigation of cellular and molecular processes previously inaccessible. Consequently, imaging methodologies, staining protocols, and fluorescent labeling — particularly those employing genetically encoded fluorescent proteins and immunofluorescence — have resulted in a substantial increase in the capacity to examine cellular structures, dynamics, and functions (Swedlow et al. 2009; Peng et al. 2012; Chessel 2017; Schneider et al. 2019; Moen et al. 2019).
As with any significant advance in today’s world, software is required to facilitate the acquisition, analysis, management, and visualization of image data resulting from these techniques. The current techniques have allowed the capture of biological phenomena with an unparalleled level of complexity and resolution (Eliceiri et al. 2012). As a result, an ever-growing amount of image data is being generated (Peng et al. 2012). Alongside the three spatial dimensions, images now encompass additional dimensions like time and color channels. Biomedical images exhibit this high level of complexity, as evidenced by the analysis of dense cell turfs where cells may partially overlap (Peng 2008; Swedlow et al. 2009). The increase in complexity demands computational approaches. Nevertheless, the challenge posed is not solely due to complexity. As imaging technology advances, the volume of image data generated from experiments also sees a steep rise (Peng 2008; Caicedo et al. 2017).
The need for quantitative information from images to understand and develop new biological concepts has led to the emergence of bioimage informatics as a specialized field of study (Eliceiri et al. 2012; Murphy 2014). Bioimage informatics is primarily concerned with the extraction of quantitative information from images to interpret biological concepts or develop new ones (Chessel 2017; Schneider et al. 2019; Moen et al. 2019). Bioimage informatics focuses on the automation of objective and reproducible image data analysis, while concurrently developing tools for the visualization, storage, processing, and analysis of such data (Swedlow and Eliceiri 2009; Peng et al. 2012). Crucial advancements range from cell phenotype screening, drug discovery, and cancer diagnosis to gene function, metabolic pathways, and protein expression patterns. The basic operations in bioimage informatics are feature extraction and selection, segmentation, registration, clustering, classification, annotation, and visualization (Peng 2008).
Due to recent advancements, the utilization of microscopy in biology has evolved
into a quantitative approach, as opposed to solely a visual one. Thus, various
essential open-source platforms, applications, and languages have emerged, which
have now become well-established within the life science community
(Paul-Gilloteaux 2023). Python, R, and MATLAB are among the most favored
programming languages in bioinformatics (Giorgi et al. 2022), with Python and R being
extensively used in biomedicine (Roesch et al. 2023). R plays a pivotal role in the
fields of statistics, bioinformatics, and data science. It is a versatile
statistical software that is used in various assays, for example, in gene
expression analyses (Rödiger et al. 2013, 2015a; Burdukiewicz et al. 2022; Chilimoniuk et al. 2024). Furthermore, it is
one of the top ten most prevalent programming languages across the globe, with a
thriving community that has developed numerous extensions and packages for
various applications (Giorgi et al. 2022). Originally developed for statistical
analysis, R and its packages now offer robust capabilities for image analysis
and automation (Chessel 2017; Haase et al. 2022). The growing demand for
automation and data-driven analysis underscores the necessity for flexible and
integrated computational tools. R’s expanding
ecosystem of packages, ranging from general-purpose image processing to
specialized, domain-specific workflows, facilitates the creation of customized
solutions tailored to diverse research needs. The extensible framework and
robust statistical capabilities support seamless integration of image analysis
with downstream data interpretation, promoting reproducibility and efficiency
across the entire analytical pipeline (Rödiger et al. 2015b; Chessel 2017; Giorgi et al. 2022; Haase et al. 2022).
R can integrate with other programming languages through the use of packages
such as reticulate (Ushey et al. 2024) for Python, which enables users to leverage
the strengths of multiple languages within their research workflows, enhancing
flexibility across diverse domains. Another example of this is
Bio7. Bio7 is an open-source platform designed for ecological modeling,
scientific image analysis, and statistical analysis. It provides an R
development environment and integration with the ImageJ application
(Austenfeld and Beyschlag 2012). ImageJ is a widely-used, public-domain
Java-based software suite specifically developed for biological image processing
and analysis, that supports various file formats, advanced image manipulation
techniques, and a vast array of plugins and scripts (Schneider et al. 2012).
A common difficulty in bioinformatics is the large number of file formats, some
of which are proprietary. A lack of standardization means that general tools
must deal with this vast array of file formats. The open-source approach
provides access to the code of applications, packages, and extensions, thereby
facilitating modification and further development by the community. This
enhances reproducibility and validation, offering flexibility and adaptability
for scientific discovery. This makes open-source methods ideally suited to the diverse
and interdisciplinary field of biological imaging research (Swedlow and Eliceiri 2009; Rödiger et al. 2015b). The Open Microscopy Environment (OME) offers a standardized,
open-source framework for the management, analysis, and exchange of biological
imaging data, with a particular focus on the integration and preservation of
rich metadata — such as experimental conditions, cell types, acquisition
parameters, microscope specifications, and quantification methods
(Goldberg et al. 2005). A central objective of OME is to ensure lossless storage and
interoperability across diverse proprietary and non-proprietary platforms. This
objective addresses the common issue of metadata loss during format conversions
within image analysis pipelines. By establishing standardized formats and
protocols, OME fosters compatibility between proprietary systems and enhances
reproducibility. The widely adopted OME-TIFF format extends the traditional TIFF
structure by embedding metadata in XML, enabling efficient storage and retrieval
of large, multidimensional datasets commonly encountered in fluorescence imaging
(Linkert et al. 2010; Leigh et al. 2016; Besson et al. 2019). In addition, the OME-ZARR format,
developed under the Next-Generation File Format (NGFF) initiative, has been
optimized for scalable, cloud-based storage of large N-dimensional arrays, with
metadata stored in human-readable JSON. The system’s capacity for partial data
access is a notable feature, contributing to enhanced performance in distributed
workflows by combining formats such as OME-TIFF, Hierarchical Data Format 5
(HDF5), and Zarr (Moore et al. 2021, 2023)1.
Increasing adoption of these formats by commercial imaging software vendors
further strengthens their relevance and sustainability (Linkert et al. 2010). In the
context of R-based workflows, the RBioFormats package provides a native
interface to the OME Bio-Formats Java library. This enables the reading of
proprietary file formats and associated metadata, output to OME-TIFF, and
seamless integration of image acquisition with downstream analysis
(Andrzej Oleś, John Lee 2023). This facilitates the establishment of flexible,
standardized, and reproducible image analysis pipelines within the R ecosystem.
The heterogeneous and dynamic nature of images presents a constant challenge for
image analysis. Capturing precise and high-quality images that accurately
represent the changing characteristics of an experiment can be difficult, even
for experienced researchers (Swedlow et al. 2009). Additionally, visualizing and
analyzing multi-gigabyte data sets requires substantial computational power. The
process of detailed analysis of image sequences, which involves identifying and
tracking objects, followed by the presentation of the resulting data and the
exploration of the underlying biological mechanisms, adds further complexity
(Swedlow and Eliceiri 2009). To at least simplify the process of selecting the
appropriate software, this review provides an overview of R packages suitable
for image analysis and outlines their applications in biological laboratory
settings.
In this study, a review of the literature was conducted over the period
September 2023 to March 2024. The objective was to identify and analyze R
packages that are suitable for bioimage informatics applications. The primary
resources included the Comprehensive R Archive Network
(CRAN)2, GitHub
repositories3, rOpenSci’s
r-universe4, the
Bioconductor repository5,
OpenAlex database, PubMed, and Google Scholar. The chosen sources allowed for an
extensive coverage of R package repositories while also providing access to
relevant scientific literature. By combining these resources, the study aimed to
provide a comprehensive overview of available tools and techniques within the
domain of bioimage informatics using R.
The search strategy centered around pertinent keywords, including “bioimage,” “biomedical image analysis,” “imaging,” “microscopy,” “histology,” and “pathology” and the following search strings:
https://openalex.org/works?page=1&filter=title_and_abstract.search%3Aimage%20processing%20in%20R
https://scholar.google.de/scholar?hl=de&as_sdt=0%2C5&q=image+analysis+in+R&btnG=
https://scholar.google.de/scholar?hl=de&as_sdt=0%2C5&q=bioimage+analysis+in+R&btnG=
https://scholar.google.de/scholar?hl=de&as_sdt=0%2C5&q=microscopy+imaging+analysis+in+R&btnG=
The identified packages were then subjected to an analysis to understand their usage, dependencies on other libraries, repository hosting platforms, and licensing terms.
The examples provided, along with this review, were created using RMarkdown. All
computations were performed using the R programming language, version 4.3.3, on
a 64-bit x86_64-pc-linux-gnu platform with the Ubuntu 22.04.3 LTS operating
system. We utilized the RStudio Integrated Development Environment
(IDE, 2023.09.0+463 “Desert Sunflower”, Ubuntu Jammy).
This review will examine a variety of R packages designed for image analysis,
including both general-purpose tools and those crafted for specific
applications. This overview aims to demonstrate the diverse capabilities and
adaptability of these tools within and beyond biological research contexts.
Given the significant interest in the localization of microplastics in cells and
the environment, our examples will primarily focus on the analysis of microbead
particles made of polymethylmethacrylate (PMMA), which measure approximately 12
µm and fall within the microplastic size range (Geithe et al. 2024). As microbeads
are round, spherical objects in images, they visually resemble other commonly
imaged objects such as seeds and cells.
Image segmentation is a crucial preliminary step in image analysis and interpretation. It involves dividing an image into distinct regions by assigning a label to each pixel. The primary objective is to delineate regions pertinent to the specific task (Peng 2008; Ghosh et al. 2019; Niedballa et al. 2022a). This process frequently employs features such as pixel intensity, gradient magnitude, or texture measures. Based on these features, segmentation techniques can be classified into three categories: region-based, edge-based, or classification-based. Classification-based methods assign class labels to pixels based on their feature values, whereas region-based and edge-based techniques focus on within-region homogeneity and between-region contrast. One straightforward method of segmentation is thresholding, which involves comparing pixel values against one or more intensity thresholds. This process typically separates the image into foreground and background regions (Sonka and Fitzpatrick 2000; Jähne 2002).
Another image segmentation method was proposed by Ren and Malik (2003). This approach integrates a preprocessing step that segments the image into superpixels, feature extraction based on Gestalt cues, evaluation of the extracted features, and the training of a linear classifier. Superpixels are clusters of pixels that are similar with respect to properties such as color and texture, resulting in larger subregions of the image. The primary objective of this preprocessing step is to simplify the image and reduce the number of regions considered for segmentation. Previously, this involved evaluating every single pixel. The division of the image into regions larger than pixels but smaller than objects allows for the superpixels to encompass a greater quantity of information, adhere to the boundaries of natural image objects, reduce the presence of noise and outliers, and enhance the speed of the subsequent segmentation process. In summary, this method can be described as segmentation based on low-level pixel grouping (Ren and Malik 2003; Hossain and Chen 2019; Mouselimis et al. 2023).
However, segmentation is not limited to the differentiation of the foreground and background. Pixel classification plays a critical role in a number of applications, including visual question answering, object counting, and tracking. In these applications, classification occurs not just spatially but also temporally. These applications are diverse, encompassing fields such as traffic analysis and surveillance, medical imaging, and cell biology (Ghosh et al. 2019). While a relatively straightforward technique, thresholding has inherent limitations in distinguishing between background, noise, and foreground. Therefore, the next section will offer a more sophisticated approach, by presenting a package that utilizes deep learning for image segmentation (Smith et al. 2021).
imageseg: a deep learning package for forest structure analysisBy venturing beyond the traditional laboratory setting, the imageseg package
offers a unique approach to analyzing forest structures through deep
learning-based image segmentation, utilizing TensorFlow
(https://www.tensorflow.org/). This R package employs the power of
convolutional neural networks with the U-Net architecture to streamline image
segmentation tasks (Niedballa et al. 2022a). According to the authors, this R
package has been designed to be user-friendly, with pre-trained models that
require only input images, making it accessible even to those without specialist
knowledge. A comprehensive vignette accompanies the package, which provides
detailed instructions on how to set up the software and explains how to utilize
its functions effectively (Niedballa et al. 2022c). Developed primarily for forestry and
ecology applications, imageseg includes pre-trained data sets representing
various aspects of forest structure, such as canopy and understory vegetation
density. Its flexibility allows for customization with different training data,
enabling users to develop customized image segmentation workflows for other
fields such as microscopy and cell biology. The package supports both binary and
multiclass segmentation. For image processing within the R programming
environment, the imageseg package integrates with the magick package (Niedballa et al. 2022a).
EBImage: specialized segmentation strategy for touching objectsThe segmentation of closely adjacent objects, which is particularly prevalent in
cell microscopy, represents a common challenge that is addressed by the
EBImage package, which is equipped with a variety of segmentation algorithms.
A typical approach involves the application of either global or adaptive
thresholding, followed by connected set labeling, with the objective of
distinguishing individual objects. To achieve more precise segmentation
of touching objects, techniques such as watershed transformation or Voronoi
segmentation are employed (Pau et al. 2010).
The watershed algorithm is employed to delineate touching microbeads (Figure 1A-C). Initially, the image is transformed into a binary image by applying a threshold (Figure 1B). After utilizing the watershed function the result is visualized by assigning distinct colors to the microbeads, effectively illustrating the algorithm’s capacity to differentiate between touching objects (Figure 1C).
# Load necessary library
library(EBImage)
# Load the image from the specified path
image <- readImage("figures/beads.png")
# Display the original image
EBImage::display(image)
# Apply a threshold to the original image to create a binary image
img_thresh <- thresh(image, offset = 0.05)
# Read the binary image and display it
EBImage::display(img_thresh)
# Perform watershed segmentation on the distance map of the thresholded image
segmented <- EBImage::watershed(distmap(img_thresh))
# Color the labels of the segmented image
segmented_col <- colorLabels(segmented)
# Display the resulting image after watershed segmentation
EBImage::display(segmented_col)


Figure 1: Watershed Segmentation in EBImage: A) Original image used for watershed segmentation in EBImage. B) The thresh() function was employed to generate a binary image with the objective of effectively separating the foreground from the background. The binary representation of the image facilitates further segmentation processes by simplifying the image. C) Presents the result of the watershed segmentation, which is visually represented by the assignment of a distinct color to each object. This technique is particularly effective in differentiating touching objects, as evidenced by the clear separation of microbeads in the image.
The primary objective of feature extraction is to condense the original data into significant objects that encapsulate crucial information pertinent to each specific image (Jude Hemanth and Anitha 2012). Feature extraction may be applied to a predefined region of interest (ROI) or may involve the identification of the ROI, a process often referred to as segmentation, which was reviewed in the previous sections. Within any given ROI, a multitude of attributes typically exist, representing different states of the object under analysis. These attributes, or features, are of vital importance for the interpretation of the detected objects and can enable applications such as disease diagnosis or the identification of promising candidates. Features related to individual pixels may include aspects such as neighborhood relationships, connectivity, and gradients, which are one-dimensional descriptions. Nevertheless, more intelligible and interpretable information is frequently derived from descriptions of regions or objects (Sonka and Fitzpatrick 2000; Shirazi et al. 2018). Object-level features encompass a range of characteristics, including size, shape, texture, intensity, and spatial distribution. Shape features can be further categorized into specific characteristics, including perimeter, radius, circularity, and area. It is crucial to acknowledge that the successful extraction of object features is dependent on the quality and accuracy of the image segmentation process (Shirazi et al. 2018).
This section is devoted to an examination of R packages that enable the
automated extraction of quantitative features. The biopixR package offers
automated and interactive object detection strategies. The pliman package,
initially developed for the analysis of plant images, has the potential to be
adaptable to a range of different domains. The FIELDimageR package is capable
of supporting the analysis of drone-captured images from agricultural field
trials as well as images from pollen, which exhibit similar characteristics to
cellular images. These tools provide novel perspectives for interdisciplinary
research, facilitating the adaptation of methodologies across diverse fields.
biopixR: versatile biological image processingThe biopixR package is a comprehensive toolbox developed primarily for
microbead analysis. It encompasses a range of functions, including image
importation, preprocessing, segmentation, feature extraction, and clustering.
The primary objective is to enable the detection of objects and the extraction
of quantitative data, including intensity values, shape, and texture
characteristics. These functionalities are integrated into user-friendly
pipelines that support batch processing, thereby enhancing accessibility. The
preprocessing capabilities include edge restoration and a variety of filter
functions (Brauckhoff et al. 2024).
To illustrate the feature extraction process, the analysis focuses on a
microbead image (Figure 2A). The image is initially converted to
grayscale. Afterwards the objectDetection() function is applied to detect image
objects. The extracted objects are then represented visually by plotting the
highlighted contours of the objects and enumerating the microbeads according to
their cluster IDs, thus distinguishing them as individual entities (Figure
2B).
# Loading necessary package
library(biopixR)
# Importing the image
beads <- importImage("figures/beads2.jpg")
# Plot original image
beads |> plot(axes = FALSE)
# Converting the image to grayscale
beads <- grayscale(beads)
# Detecting objects in the image using edge detection
objects <-
objectDetection(beads, # Image to process
method = 'edge', # Method for object detection
alpha = 1, # Threshold adjustment factor
sigma = 0) # Smoothing factor
# Displaying internal visualization of object detection with marked contours
# and centers
objects$marked_objects |> plot(axes = FALSE)
# Adding text annotations at the centers of detected objects
text(objects$centers$mx, # x-coordinates of object centers
objects$centers$my, # y-coordinates of object centers
objects$centers$value, # Text to display (value of the object center)
col = "green", # Color of the text
cex = 1.5)

Figure 2: Microbead Detection using biopixR: A) The original image shows red fluorescent microbeads, with the majority appearing as isolated, round, spherical objects. Some microbeads are clustered together or overlapping, forming aggregated structures, while others are partially captured within the image frame. B) In the grayscale microbead image, edges of the microbeads are highlighted in purple, and the labeling ID (value) is displayed at the center of each object in green.
pliman: an R package for plant image analysispliman is designed to analyze plant images, particularly leaves and seeds, to
help identify disease states, lesion shapes, and quantify objects. It
supports various functions, including image transformation, binarization,
segmentation, and detailed analysis, all facilitated by a detailed
vignette.6 A key feature of pliman is its automation of quantitative feature
extraction (Figure 3 and 4), which
traditionally requires manual, time-consuming, and error-prone methods. The
features of this package are versatile, encompassing a range of segmentation
strategies, the analysis of shape and contour characteristics of leaves and
seeds, the counting of objects, and the quantification of disease states from
leaf images. While the primary focus is on plant imaging, the techniques used
are applicable to other fields such as cellular imaging. This
cross-applicability is further emphasized by the package’s batch processing
capabilities, which allow for autonomous analysis of multiple images, critical
for high-throughput phenotyping tasks (Olivoto 2022).
# Loading necessary package
library(pliman)
# Import requires EBImage:
# Importing the main image
beads <- EBImage::readImage("figures/beads2.jpg")
# Importing additional images for background and foreground
foreground <- EBImage::readImage("figures/foreground.jpg")
background <- EBImage::readImage("figures/background.jpg")
# Displaying the microbead image
EBImage::display(beads)
# Combining the foreground and background images and arranging them in 2 rows
pliman::image_combine(foreground, background, nrow = 2, col = "transparent")

Figure 3: Preparing Segmentation using pliman: The image comprises two sections. On the left, an image of microbeads is displayed. On the right, a cropped view from the same image illustrates two states for segmentation: the microbead (foreground) in red, and the background is shown in black, emphasizing the clear division needed for segmentation analysis.
# Performing segmentation based on provided background and foreground images
analyze_objects(
img = beads, # Main image of microbeads
background = background, # Background sample image
foreground = foreground, # Foreground sample image
marker = "id", # Displaying enumeration
contour_col = "yellow" # Color for the contour of the segmented objects
)
Figure 4: Segmentation Results using pliman: The image depicts the segmentation results obtained via the pliman analyze_objects() function. It displays the contours of the segmented objects, outlined in yellow. Each distinct object within the segmentation is numbered, facilitating its identification.
FIELDimageR: an R package for the analysis of drone-captured imagesThe FIELDimageR package, is an R package designed for the specific purpose
of analyzing drone-captured images from agricultural field trials. The package
offers a variety of functions for ROI selection, the extraction of
foregrounds (Figure 5), watershed segmentation, quantification
and shape analysis (Matias et al. 2020). The developers have applied this package to
analyze pollen, which visually resembles cells under a microscope. This suggests
that FIELDimageR may be applicable for use in microbiological image analysis.
For the spatial analysis, the package utilizes the terra package
(Matias et al. 2020).7
To showcase the functionalities of the FIELDimageR package and its parallels
with biological applications, the same microbead image is subjected to analysis.
The image is initially transformed into a ‘SpatRaster’ object and then segmented
using an intensity threshold (Figure 5). The microbeads are
correctly identified as the foreground objects by the fieldMask() function.
Subsequently, a distinct labeling ID is assigned to each microbead, as
illustrated by a color gradient. Moreover, the contours of each individual
object are displayed (Figure 6). The results of the segmentation
and the extraction of shape-related information are presented in the interactive
leaflet interface (Figure 7). Presenting information like
cluster ID, size, perimeter and width of the detected objects.
# Loading necessary packages
library(FIELDimageR)
library(FIELDimageR.Extra)
library(terra)
library(sf)
library(leafsync)
library(mapview)
# Using the same image as imported in the previous example
# Creating a SpatRaster object using the 'terra' package
EX.P <- rast("figures/beads2.jpg")
EX.P <- imgLAB(EX.P)
[1] "3 layers available"
# Removing background based on a vegetation index
EX.P.R1 <-
fieldMask(
mosaic = EX.P, # Input SpatRaster object
index = "BIM", # Index representing vegetation
cropValue = 5, # Threshold value for the index
cropAbove = F # Indicates to remove values below the threshold
)
# Displaying the original, background, and foreground images
EX.P.R1$newMosaic
Figure 5: Displaying the original, background, and foreground Images: The original image (left) shows the fluorescent microbeads. The middle image displays the background in white (TRUE) and all objects detected by segmentation in black (FALSE). The right image shows only the foreground (microbeads) after detection through segmentation using the fieldMASK() function.
# Labeling of all microbeads
EX.P.Total <- fieldCount(mosaic = EX.P.R1$mask, plot = T)
Figure 6: Labeling of Microbeads: The fieldCount() function is used to label individual microbeads. This function utilizes the mask produced in the previous section to identify the objects. The left image displays the labeling with a color gradient indicating distinct objects. On the right, the object contours are shown. The output of the function includes more than just the labeling value (named ID in this package); it also provides information on area, perimeter, width, and geometry of the detected objects.
[1] “Starting analysis …” [1] “End!”
Figure 7: Displaying Results with an Interactive leaflet Tool: The tool displays the original image on the left. For comparison, the cursor is mirrored to the corresponding image (only visible in HTML format). The left image provides detailed information interactively. Hovering over the objects reveals their labeling ID. Performing a left-click opens a detailed window providing information for the individual object, such as area, perimeter, width, and shape. The packages FIELDimageR.Extra, mapview, and leafsync are used to create the interactive display.
In summary, packages such as EBImage and biopixR provide direct pipelines
for the extraction of features from images, including shape, size, radius, and
perimeter, as well as texture information through the calculation of Haralick
texture features (Haralick et al. 1973; Pau et al. 2010; Brauckhoff et al. 2024). The biopixR package
employs the imager and magick packages for image processing (Brauckhoff et al. 2024),
whereas pliman and FIELDimageR rely on EBImage for direct image analysis,
with FIELDimageR also utilizing terra and raster for spatial data
exploration (Matias et al. 2020; Olivoto 2022). In comparison to the other packages
discussed in this section, biopixR facilitates the process of object detection
by eliminating the necessity for the generation of masks or the provision of
representative sample images of the foreground and background. Nevertheless, in
contrast to the other packages, biopixR lacks the functionality of watershed
segmentation for the enhanced handling of touching objects (Figure
2B and Figure 4) (Matias et al. 2020; Olivoto 2022; Brauckhoff et al. 2024).
The automation of measuring cellular phenomena and the effects of compounds, which started in the late 1990s, is now increasingly significant owing to the progress of machine learning (ML) algorithms and computing power. These advancements are enhancing the field of bioinformatics’ accessibility to these techniques. Consequently, they are being more commonly employed with the aim of gaining novel biological insights (Murphy 2014; Moen et al. 2019; Weiss et al. 2022). One of the latest methods of image analysis involves comparing the morphological characteristics of cells from captured images with pre-classified training data that represent a specific state (Moen et al. 2019). Bioimage informatics methods aim to generate fully automated models for biological systems (Murphy 2014).
A major challenge in handling new data sets is the need to label images, which is critical to assigning meaning to the objects within them. This is particularly important in medical imaging, where expert knowledge is essential for accurate labeling (Boom et al. 2012; Weiss et al. 2022). In ML, two common techniques that can be used to categorize data into distinct groups are clustering and classification. Clustering, an unsupervised learning method, is used to discover underlying structures or patterns in unlabeled data by assessing similarities between data points (Mostafa and Amano 2019). Classification, a form of supervised learning, involves building a model from previously labeled training data to make predictions about new data (Mostafa and Amano 2019; Kumar Dubey et al. 2022). This requires prior labeling of the data to determine the characteristics of each group, a process known as annotation. However, manual annotation is time-consuming and labor-intensive, requiring significant human effort to identify relevant details in an image (Yao et al. 2016; Weiss et al. 2022). Because images often require multi-label annotation - the assignment of multiple semantic concepts to a single image - there has been a growing demand for automated image annotation systems that aim to reduce the burden of manual labeling and increase the efficiency of data processing (Nasierding et al. 2009).
To effectively analyze complex image data sets, researchers require advanced pattern recognition techniques that can extract meaningful biological insights from these images. This enables them to transform visual data into actionable scientific knowledge (Behura 2021). Some of the most widely used clustering algorithms for this purpose include:
pixelclasser: a simplified support vector machine approach for pixel classificationThe pixelclasser package is a tool for classifying image pixels into
user-defined color categories using a simplified version of the Support Vector
Machine (SVM) technique. It includes functions that allow users to visualize
image pixels, define classification rules, classify pixels, and store the
resulting information.8 Users must
provide a test set that captures the variation between categories, as the
package requires manual placement of rules for each category - automatic rule
construction methods are not included. In addition, pixelclasser provides
quality control of the classifications and comes with a detailed vignette to
facilitate the use of this classification
tool.9
The classification on the pixel-level can be used for image segmentation via
pixel clustering.
biopixR: pattern recognition of shape- and texture-related featuresThe biopixR package incorporates two unsupervised ML clustering
algorithms: SOM and PAM. PAM organizes a distance matrix into clusters,
identifying medoids as robust representatives of each cluster, typically
specified with a predefined number of groups (k) (Kaufman and Rousseeuw 1990; Van der Laan et al. 2003; Park and Jun 2009). This approach clusters Haralick texture features
extracted from multiple images within a directory, thereby enabling image
classification based on these features (Haralick et al. 1973). The optimal number of
clusters (k) is automatically determined using silhouette analysis
(Rousseeuw 1987; Brauckhoff et al. 2024). SOM is used to cluster object features related to
object shape and intensity, thereby facilitating the identification of patterns
within these characteristics (Brauckhoff et al. 2024).
The capacity for pattern recognition within the biopixR package is
demonstrated by the clustering of shape-related and pixel-intensity information
from an example image of microbeads (Figure 8A). The image
depicts both single and aggregated microbeads, wherein the former exhibit a
round, spherical shape, while the latter appear more oval. The extracted
features and the corresponding cluster are depicted in Figure
8B, which showcases the identification of patterns within
these objects based on their shape characteristics.
# Load the 'biopixR' package
library(biopixR)
# Import an image from the specified path
img <- importImage("figures/beads.png")
# Set seed for reproducibility
set.seed(123)
# Extract shape features from the image
result <- shapeFeatures(
img,
alpha = 0.8,
sigma = 0.7,
xdim = 2,
ydim = 1,
SOM = TRUE,
visualize = FALSE
)
# Define colors for plotting points based on classes
colors <- c("darkgreen", "darkred")
# Plot the image without axes and add colored points representing the classes
img |> plot(axes = FALSE)
with(result,
points(
result$x,
result$y,
col = colors[factor(result$class)],
pch = 19,
cex = 1.2
))
text(c(471), c(354), c("A"), col = "darkred", cex = 5)
# Create a data frame with various shape features and the pixel-intensity
df <- data.frame(
size = result$size,
intensity = result$intensity,
perimeter = result$perimeter,
circularity = result$circularity,
eccentricity = result$eccentricity,
radius = result$mean_radius,
aspectRatio = result$aspect_ratio
)
# Min-Max Normalization Function
min_max_norm <- function(x) {
(x - min(x)) / (max(x) - min(x))
}
# Applying the function to each column
df_normalized <- as.data.frame(lapply(df, min_max_norm))
# Create a boxplot of the normalized data
boxplot(
df_normalized,
ylab = "normalized values",
xaxt = "n",
cex.lab = 1.25,
cex.axis = 1.25
)
# Add axis ticks and diagonal labels
axis(1, at = 1:ncol(df), labels = FALSE) # Add axis ticks but no labels
text(
cex = 1.2,
x = seq_len(ncol(df_normalized)),
y = -0.07,
labels = colnames(df_normalized),
adj = 0,
srt = -45,
xpd = TRUE
)
# Highlight specific rows based on class
highlight_rows <-
which(result$class == 2) # Example row indices to highlight
# Add points for the specific rows
# Adding points for each column
for (col in 1:ncol(df_normalized)) {
points(
rep(col, length(highlight_rows)),
df_normalized[highlight_rows, col],
col = "red",
pch = 19,
cex = 1.5
)
}
text(c(0.5),
c(0.98),
c("B"),
col = "darkred",
cex = 5)
Figure 8: Clustering Microbeads Based on Shape and Intensity Features: A) The utilization of Self-Organizing Maps (SOM) enables the clustering of microbeads into two distinct groups based on shape and intensity features extracted using the shapeFeatures() function. This method enables the precise clustering of microbeads according to a range of properties, including intensity, area, perimeter, circularity, radius, and aspect ratio. This facilitates a deeper understanding of the morphological variations observed in the microbeads. B) The attributes utilized as input for the SOM algorithm are illustrated in this plot. To ensure comparability, the different parameters have been normalized using a min-max normalization procedure. The points highlighted in red represent the microbeads that are also highlighted in red in Figure A. Notably, these highlighted points differ from the most commonly occurring values in all attributes except for the intensity.
The process of image registration plays a pivotal role in the analysis of medical images, as it enables the comparison of multiple images representing different conditions (Jenkinson and Smith 2001). This process, which can be described as image alignment, entails aligning a series of images within a single coordinate system, thereby ensuring consistency across images (Peng 2008; Rittscher 2010). A variety of techniques are employed in image registration, including mutual information registration, spline-based elastic registration, and invariant moment feature-based registration, among others (Peng 2008). These methods are of particular significance in the field of medical imaging, where they are employed to enhance the analysis of images obtained by techniques such as computed tomography (CT) and magnetic resonance imaging (MRI) (Sonka and Fitzpatrick 2000).
RNiftyReg: interface for the ‘NiftyReg’ image registration toolsThe RNiftyReg package provides an interface to the ‘NiftyReg’ image
registration library, which supports both linear and non-linear registration in
two and three dimensions (Clayden et al. 2023). This package has been utilized in
research on brain connectivity (Clayden et al. 2013), and it includes a comprehensive
README that introduces its features and
capabilities.10
R packages for broad-spectrum analysisFive principal image processing packages for R offer a broad range of
algorithms and capabilities for complete image analysis, rendering them
suitable as general-purpose tools. These packages are imager, magick,
EBImage, OpenImageR and SimpleITK. This section will introduce each of
these key packages and their roles in image analysis.
imager: wrapper for the ‘CImg’ C++ image processing libraryThe imager R package, created by Barthelmé and Tschumperlé (2019), integrates the
functionality of the ‘CImg’ library, developed by David Tschumperlé, into
R.11 This allows users
to edit and create images. The package uses two primary data structures: raster
images, known as cimg, and pixel sets, referred to as pixelset. These
structures, encoded as four-dimensional numeric or logical arrays, permit the
execution of basic R functions such as plot(), print(), or
as.data.frame(), as well as the processing of hyperspectral images and videos
(Barthelmé and Tschumperlé 2019). The 4D arrays encompass two spatial dimensions (width and
height), one temporal or depth dimension, and one color dimension (Barthelme et al. 2024).
imager offers over 100 standard commands for tasks such as loading, saving,
resizing, and denoising of images.12
The imager package supports the file formats JPEG, PNG,
and BMP and is available on CRAN (Barthelme et al. 2024).
EBImage: image processing and analysis for biological imaging data in RThe EBImage package, established in 2006, is one of the oldest image
processing tools available in R and can be accessed via the Bioconductor
repository. It is primarily written in R and C/C++ (Andrzej Oleś 2017).
EBImage provides a suite of general tools for image processing and analysis,
particularly excelling in microscopy-based cell assays. It features specialized
commands for cell segmentation and the extraction of quantitative data from
images (Pau et al. 2010). The package employs the RGB color system for color
detection, which is based on pixel intensities. The incorporation of the
EBImage package into the R workflow facilitates the automation and objectivity
of the image analysis procedure (Heineck et al. 2019). Images in EBImage are
managed as an extension of R‘s base array, specifically the package-specific
Image class. As images are treated as multidimensional arrays, algebraic
operations are possible. This class structure includes various slots, with the
.data slot holding the numeric pixel intensity array and the colorMode slot
managing the image’s color information. Adjusting the colorMode setting
changes the image’s rendering mode (Andrzej Oleś 2017; Heineck et al. 2019).
Typically, the first two dimensions of an image carry spatial information, while
additional dimensions are variable and can represent color channels, time
points, replicas, or depth. EBImage also features an interactive display
interface through GTK+, and offers a set of functions for
automated image-based phenotyping in biology, including cell segmentation,
feature extraction, statistical analysis, and visualization (Pau et al. 2010). It
supports a range of file formats, including JPEG, PNG, and TIFF, and can handle
additional formats through integration with the ’ImageMagick’ image-processing
library (Pau et al. 2010; Andrzej Oleś 2017).
magick: advanced image processing in R using ‘ImageMagick’This package is built upon ‘Magick++’, the C++ API for the ‘ImageMagick’ image
processing library.13 The R package provides access to ‘ImageMagick’
functionalities, enabling both basic and complex image manipulations directly in
R. Notably, images in magick are automatically displayed in the RStudio
console, creating a dynamic and interactive editing environment. The wide
variety of functions made available through this package are impressive. The
possibilities range from functions that are rather ‘just for fun’, such as
implosion or introduction of noise, to more advanced processing techniques,
including different segmentation techniques, edge detection, and a
toolbox for morphology operations. The magick package is compatible with a
diverse range of image formats and encompasses the functionalities required for
format conversion. This includes the conversion to the formats supported by the
EBImage package. It also handles multiple frames, facilitating the creation
and processing of animated graphics. Each operation in magick creates a new,
altered version of the image, preserving the original
(Ooms 2024a).14 Recent developments include the introduction of a shiny
application that enables users to interactively perform basic image processing
tasks such as blurring and edge
detection.15
The magick package is compatible with a range of popular file formats,
including PNG, BMP, TIFF, PDF, SVG, and JPEG, and is available through the CRAN
repository (Ooms 2024a).16
OpenImageR: a general-purpose image processing libraryOpenImageR is a lesser known but highly versatile general-purpose image
processing library that integrates both the R and C++ programming languages.
This package offers a comprehensive array of functions for preprocessing,
filtering, and feature extraction. Images are treated as two- or
three-dimensional objects, represented by matrices, data frames, or arrays, with
the third dimension representing color information. The functionalities within
OpenImageR are organized into three main categories: basic functions, which
include importing, displaying, cropping, and thresholding; filter functions,
which feature augmentation and various edge detection algorithms; and image
recognition, which incorporates functions from the ‘ImageHash’ Python library.
In recent updates, a number of new features have been incorporated, including
Gabor feature extraction, which was originally developed in MATLAB and based on
code by Haghighat et al. (2015). The most recent version incorporates image segmentation
techniques that utilize superpixels and clustering. Images can be visualized
through the shiny application or the grid package. OpenImageR is capable of
handling a multitude of image formats, including PNG, TIFF, and JPG
(Mouselimis et al. 2023).17 18
SimpleITK: a streamlined wrapper for ITK in biomedical image analysisThe following section will introduce a prominent tool in biomedical image
analysis, the wrapper for the Insight Segmentation and Registration Toolkit
(ITK), known as SimpleITK (Rittscher 2010). SimpleITK represents a
streamlined version of the original ITK, an open-source C++ library that
features a wide array of imaging algorithms and frameworks
(Lowekamp et al. 2013; Yaniv et al. 2017). This library has been in development for
approximately two decades and is particularly favored in the medical image
analysis community (Lowekamp et al. 2013; Beare et al. 2018).
The objective of SimpleITK is to simplify the accessibility of ITK algorithms
by reducing their complexity, thereby making these sophisticated tools more
approachable for a broader audience (Lowekamp et al. 2013). Adapted for the R
programming language through SWIG, SimpleITK offers over 250 image processing
algorithms that function across various scripting and prototyping environments
(Lowekamp et al. 2013; Yaniv et al. 2017; Beare et al. 2018). In contrast to other general-purpose
image processing packages, which treat images as mere arrays, SimpleITK treats
images as objects within a physical space, thereby providing a set
of metadata about image and voxel geometry in world coordinates (Lowekamp et al. 2013; Yaniv et al. 2017; Beare et al. 2018). This nuanced representation is of particular
importance for specific medical imaging applications. Additionally, SimpleITK
incorporates metadata such as the origin, pixel spacing, and a matrix defining
the physical orientation of image axes (Yaniv et al. 2017). However, the complexity
of the underlying ITK library may impede customization and necessitate
familiarity with C++. Another challenge for R developers arises from the fact
that the documentation is also based on C++ (Beare et al. 2018). To facilitate the
learning process, Yaniv et al. (2017) has developed a series of Jupyter notebooks that
provide an introduction to the package and its capabilities for both Python and
R users. These notebooks serve as educational tools and a resource for research,
providing full coverage of the entire spectrum of image analysis
processes
(Beare et al. 2018).19
In combination with R, SimpleITK enables detailed image processing and
facilitates the subsequent statistical evaluation of quantified data. The
software is compatible with a range of digital image formats, including JPEG,
BMP, PNG, and TIFF, and is capable of analyzing 2D and 3D images
(Beare et al. 2018). The package is obtained through the GitHub
repository.20
In summary, these packages and their associated libraries offer a vast array of
algorithms that can be accessed in R. This includes features from the ‘CImg’,
‘ImageMagick’ and ITK libraries, along with the diverse algorithms encoded in the
EBImage package. These flexible packages provide the foundation for the
development of numerous tailored applications.
RMultiplexed imaging is a crucial technology for analyzing complex biological processes at the single-cell level, especially in tissue-based cancers and autoimmune diseases (Harris et al. 2022b). This technique enables the simultaneous assessment of multiple protein and DNA molecules, overcoming limitations that hinder advancements in understanding biological interactions and phenomena (Gerdes et al. 2013; Goltsev et al. 2018). Multiplex imaging is the result of a multiplex experiment, in which multiple species (Aherne et al. 2024), biomolecules (Damond et al. 2019), or cell types (Creed et al. 2021) are labeled with different probes, dyes, or antibodies simultaneously. This technique allows for the differentiation of components within the resulting image (Eling et al. 2020). In comparison to standard immunofluorescence experiments, the number of distinct targets is significantly increased, reaching up to 50 different target molecules (Damond et al. 2019; Einhaus et al. 2023). This can be used to distinguish between species in a biofilm (Aherne et al. 2024), or to obtain an overview of the biomarker distribution or tissue composition in a sample (Damond et al. 2019; Yang et al. 2020). The technique has the capacity to reveal the positions and interactions of individual cells, provide insight into the activities of biomolecules, and holds the potential for the reconstruction of the three-dimensional tissue architecture of a given sample (Harris et al. 2022a; Cho et al. 2023; Zhao and Germain 2023). Several imaging techniques are used to obtain detailed insights into the spatial interactions between cells, including Co-Detection by indEXing (CODEX) (Goltsev et al. 2018), Multiplex Ion Beam Imaging (MIBI) (Angelo et al. 2014), and Multiplexed Immunofluorescence Imaging (MxIF) (Gerdes et al. 2013; Harris et al. 2022b; Feng et al. 2023). These methods generate vast amounts of imaging data, often terabytes across hundreds of slides, which necessitates sophisticated image analysis pipelines (Harris et al. 2022a).
mxnorm: normalize multiplexed imaging dataManaging technical variability within these pipelines is crucial, and intensity
normalization is one approach to address this issue (Harris et al. 2022a). The R
package mxnorm addresses this by providing tools for implementing, evaluating,
and visualizing various normalization techniques (Harris 2023). These tools aid in
measuring technical variability and evaluating the efficacy of various
normalization methods. They enable users to apply customized methods to improve
image consistency by reducing technical variations while preserving biological
signals. mxnorm provides an analysis pipeline for multiplex
images, incorporating normalization algorithms inspired by the ComBat paper,
the fda package, and the tidyverse framework (Harris et al. 2022b). For researchers
who want to effectively standardize multiplexed imaging data, these features
make mxnorm a powerful resource (Harris 2023).
DIMPLE: manipulation and exploration of multiplex imagesTo assess patient outcomes, understand disease mechanisms, and develop effective
cancer therapies, the DIMPLE R package is designed to extract critical
information from the tumor microenvironment (TME). DIMPLE facilitates
quantification and visualization of cellular interactions within the TME using
spatial data. It also enables correlation of these interactions and phenotypic
data with patient outcomes through sophisticated statistical modeling. DIMPLE
provides researchers with an extensive toolkit to analyze cellular
interactions and transform raw multiplex imaging data into actionable biological
insights, potentially identifying prognostic indicators for cancer research and
therapy development. To support the analysis process, a shiny application is
provided (Masotti et al. 2023).21
cytomapper: visualization of multiplex images and cell-level informationThe cytomapper package is designed to visualize multiplexed read-outs and
cell-level information obtained by multiplex imaging
technologies (Nils Eling, Nicolas Damond, Tobias Hoch 2020). It offers various
functions to view pixel-level information across multiple channels and display
expression data for individual cells. Additionally, cytomapper includes
features to gate cells based on their expression values, enhancing the analysis
of complex data sets. It is compatible with data from various multiplex imaging
technologies and requires single-cell read-outs, multi-channel TIFF stacks,
and segmentation masks. The cytomapper package is a versatile tool for
researchers working with advanced imaging data sets to explore cellular behaviors
and properties (Eling et al. 2020).
SPIAT: analyzing spatial properties of tissuesThe SPIAT package, standing for Spatial Image Analysis of
Tissues, is among the most comprehensive tools for multiplex image analysis
(Trigos et al. 2022). Developed with compatibility for multiplex imaging
technologies like CODEX and MIBI, SPIAT facilitates the analysis of spatial
data by using X and Y coordinates of cells, their marker intensities, and
phenotypes. It features six analysis modules that support a variety of functions
including visualization, cell co-localization, distance measurements between cell
types, categorization of the immune microenvironment in relation to tumor areas,
analysis of cellular neighborhoods and clusters, and quantification of spatial
heterogeneity (Yang et al. 2020; Trigos et al. 2022). To use SPIAT, images must be
pre-segmented and cells phenotyped, typically using external software like HALO
and InForm to prepare the correct input format (Yang et al. 2020). The package
provides a shiny application that assists the user in formatting spatial data
from the aforementioned sources in a manner that ensures compatibility with the
functions of the SPIAT package.22
SPIAT is designed to be user-friendly, making complex spatial analysis
accessible to researchers with varying computational skills (Feng et al. 2023).
Seurat: spatially resolved transcriptomics (SRT)Spatially resolved transcriptomics (SRT) is a commonly used approach for the
quantification of gene expression levels in tissue sections while preserving
positional information (Larsson et al. 2023). The Seurat package
(Hao et al. 2024) is a package for spatial transcriptomics and multiplexed
imaging analysis. It shares some similarities with the SPIAT and spatialTIME
packages. For assays with cell segmentation, Seurat facilitates the
visualization of individual cell boundaries or centroids, thereby enabling more
precise mapping of molecular signals to cells. In contrast to other reviewed
packages, Seurat’s unique feature is its integration of spatial and molecular
data for spatial data analysis. In particular, it enables the joint analysis of
spatially-resolved gene expression data alongside traditional single-cell
RNA-seq, allowing researchers to map cell types and states within their native
tissue context, along with metadata. Notably, Seurat supports the analysis and
visualization of spatial omics data at both single-cell and subcellular
resolution. Seurat deliberately supports a broad range of spatial
technologies, including the Akoya CODEX/Phenocycler platform and
sequencing-based platforms such as Visium Spatial Gene Expression, 10x Genomics
and Slide-seq. To achieve these capabilities, Seurat offers statistical
methods to identify genes or features with spatially structured expression
patterns, which facilitate the uncovering of region-specific biological
processes. Since its first publication in 2015 (Satija et al. 2015), its
functionality has expanded to include support for image-based spatial
transcriptomics (highly multiplexed imaging technologies). Seurat uses image
data (e.g., raw, masked, processed images, 10X Genomics Visium Image).
spatialTIME: spatial analysis of Vectra immunofluorescence dataThe spatialTIME package has been designed for the analysis of
immunofluorescence data with the objective of identifying spatial patterns
within the TME. The package appears to be designed to work with data acquired by
the Vectra Polaris™ imaging
system.23
It facilitates the spatial analysis of multiplex
immunofluorescence data, enabling spatial characterization and architectural
reconstruction. Additionally, the package includes a shiny application,
iTIME, which offers a user-friendly point-and-click interface that mirrors
many of the capabilities found in spatialTIME
(Creed et al. 2021).24
The package also comes with a detailed vignette to help users get started with
its features (Creed et al. 2024).
In summary, R offers a range of tools for analyzing multiplex imaging data.
However, it is important to note that these packages, except for the
cytomapper package, require image preprocessing and use the resulting data
frames as input for analysis.
R packages for analyzing cellular movement dynamicsCellular migration is essential for various physiological and pathological functions, including development, immune responses, wound healing, and tumor progression (Bise et al. 2011; Yamada and Sixt 2019; Hossian and Mattheolabakis 2020), making it a crucial field in disciplines such as neuroscience, oncology, and regenerative medicine (Kaiser and Bruinink 2004; Hu et al. 2023). To gain insight into these biological processes, researchers can track cell movement by manually tracing their positions in sequential images for 2D coordinates or by incorporating the z coordinate for 3D analysis (Hu et al. 2023). By studying cell migration at multiple levels - from the molecular components and the behavior of individual cells to the dynamics of cell populations - researchers can unravel the complex interactions that influence the movement of cells (Maheshwari and Lauffenburger 1998). Such wide studies are crucial in advancing our understanding of phenomena such as cancer metastasis, which could lead to new therapeutic strategies (Um et al. 2017).
celltrackR: analyzing motion in two or three dimensionsThe celltrackR package is intended for analyzing motion in two or three
dimensions, primarily using data from time-lapse microscopy or x-y-(z)
coordinates. It is useful in both biological settings for tracking cells and in
non-biological contexts for object tracking (Textor et al. 2024). Additionally, the
package provides a web user interface to facilitate the analysis
process.25 The package contains
standard analytical tools, such as mean square displacement and autocorrelation,
as well as algorithms for simulating artificial tracks using various models,
such as Brownian motion and the Beauchemin model of lymphocyte migration
(Textor et al. 2024). Furthermore, celltrackR provides a complete pipeline for
track analysis, including data management, quality control, and methods for
detecting tracking errors, such as track interpolation and drift correction
(Wortel et al. 2021). The package is well-documented, providing detailed vignettes that
guide users through the migration analysis process (Textor et al. 2024).
In this section, we explore the use of R tools for analyzing spatial
properties in applications such as transcriptomics. One notable package is the
MoleculeExperiment package (MoleculeExperiment 2024), which
can be used to analyze molecular data within image-based data sets. This package
builds upon other popular packages like EBImage, focusing on raster analysis,
and terra (Hijmans 2024) for handling geographic information systems (GIS) tasks.
Raster or gridded data are spatial data structures that divide regions into
rectangles called cells or pixels, storing one or more values. These grids
contrast with vector data representing points, lines, and polygons in GIS
contexts. Each pixel represents an area on a surface, making color image rasters
unique due to their multiple bands containing reflectance values for specific
colors or light spectra.
The terra package (formerly known as raster/sp) offers fast operations
through optimized back-end C++ code. Users can perform various raster tasks such
as creating objects, executing spatial/geometric functions like re-projections
and resampling, filtering, and conducting calculations. Functions within the
package facilitate extracting essential statistics from entire SpatRaster
data sets, including mean values, maximum values, value ranges, or counts of NA
cells. In addition to these analytical capabilities, terra provides
functionality for visualizing data and interacting with rasters, enhancing user
experience when working with gridded spatial information. This versatility makes
the package an essential tool in analyzing transcriptomic data within
image-based data sets using R tools (Hijmans 2020).
The R environment offers multiple additional tools for
the extraction of information from data, with a particular focus on the
extraction of measuring points in scientific diagrams. This task is of
particular significance when data is available exclusively in image format, for
instance from publications or other sources.
digitize: use data from published plots or imagesThe digitize package is a well-established and mature tool that simplifies
importing data from digital images by providing a user-friendly interface for
calibration and point location. It leverages the readbitmap package to read
various bitmap formats such as BMP, JPEG, PNG, and TIFF. When reading these
image files, digitize relies on the magic number embedded within each file
rather than solely relying on the file extension. For seamless integration with
JPEG and PNG images, this package depends on external libraries like ‘libjpg’
and ‘libpng’ (Poisot 2011). Interestingly, the packages can be
used for other purposes as well. For example, Figure 9
demonstrates that the digitize package can quantify certain structures in
images. This example illustrates how fluorescent objects in an image can be
identified by their position and subsequently quantified by their number.
Figure 9: Counting using digitize: The figure provided to digitize, consists of cells with DNA damage (similar to Rödiger et al. (2018)). The nucleus is colored with DAPI (blue) and the \(\gamma\)H2AX histone, a marker for DNA double strand breaks, is stained with a specific antibody. The digitize package is used to interactively extract the coordinates (shown in the console) by using the cursor to define the region of interest (blue cross) and tag the objects within it (red circles). In the screenshot it is displayed how digitize is invoked in RKWard (0.7.5z+0.7.6+devel3, Linux, TUXEDO OS 2, (Rödiger et al. 2012)).
juicr: extraction of numerical data from scientific imagesjuicr is a tool designed to automate the extraction of numerical data from
scientific images. It offers users a Tcl/Tk graphical user interface (GUI) that
simplifies point-and-click manual extraction with advanced features such as
image zooming, calibration capabilities, and classification options.
Additionally, juicr provides semi-automated tools for fine-tuning extraction
attempts. To ensure optimal performance, this package depends on
the EBImage package, which must be installed and loaded
prior to utilization. Once data is extracted using juicr, users can choose to
save their results in various formats including comma-separated values (CSV)
files or postscript (EPS) files for easy import into other software. Moreover,
extractions can also be saved as fully-embedded and standalone HTML files, that
preserve all extraction details, setup configurations, and image modifications.
These HTML files provide a means of storing data while ensuring long-term
accessibility and replicability for future reference and analysis purposes
(Lajeunesse 2021).
image2data: transforming images into data setsIn recent years, the conversion of images into data sets has emerged as an
essential tool in various fields such as computer vision, healthcare, and
geospatial analysis. The image2data R package provides functionality to
convert images into data sets (Caron and Dufresne 2022). The primary function image2data() takes
an image file with extensions like .png, .tiff, .jpeg or .bmp as input and
converts it into a data set. Each row of the resulting data set represents a pixel
(or subject), while columns represent variables such as x-coordinate,
y-coordinate, and hex color code. The image2data() function offers
methods for reducing data sets, yielding results akin to pixelated images with
adjustable precision values. Higher precision leads to more data points, while
lower precision yields fewer. This example showcases a pixelated representation
of a pixel-based image in PNG format, highlighting its unique visual attributes.
Users have the ability to customize and modify various elements by adjusting
their corresponding hex color codes for precise control over hues, saturation
levels, and brightness.
# Loading the required packages
library(image2data)
library(data.table)
# Path to the image file
image <- "figures/test3.png"
img <- EBImage::readImage(image)
# Subsampling the image data
beads_subsample <- image2data(
path = image, # Path to the image file
reduce = .2, # Reduction factor for subsampling
# (20 % of original number of pixels)
seed = 42, # Seed for random number generation by
# return (for reproducibility)
showplot = FALSE # Whether to show a plot of the subsampled data
) |> as.data.table() # Converting the result to a data.table
# Display a part of the subsampled data
beads_subsample
x y g
<num> <num> <char>
1: 0.1022393 -0.9263444 #2F5C61
2: -0.1022393 0.4006978 #121D11
3: 1.2449136 -0.5213380 #121B10
4: 0.4871401 -1.6588028 #151E1C
5: -0.3548305 -1.5381626 #0D1B0D
---
23151: -1.1486884 1.1159219 #352B5E
23152: -0.6074216 0.1508003 #252E60
23153: 1.4975048 0.5988925 #14180B
23154: -1.3651952 0.2025032 #2A306B
23155: 0.3428023 -0.3231434 #112048
EBImage::display(img)
# Plotting the subsampled data
plot(beads_subsample$x, # x-coordinates
beads_subsample$y, # y-coordinates
col = beads_subsample$g, # Color based on hex code extracted by image2data()
pch = 19, # Plotting character (solid circle)
xlab = "",
ylab = "")

Figure 10: Application Example of the image2data Package: The image displays nuclei stained with DAPI (blue) and a quantitative marker for DNA double strand breaks, was labeled with a specific antibody (green). The image2data package extracted 20% of the pixels from the original image (top), creating a table with x|y coordinates and corresponding hex color codes. This data was then used to reassemble the image using R’s base plot (bottom).
The analysis and processing of images to extract useful information can be a challenging endeavor. Consequently, the implementation of interactive approaches accompanied by immediate visual feedback regarding parameter alterations represents a significant aid in simplifying image analysis. Therefore, this section will focus on interactive tools and functions from packages that facilitate the exploration of images and the extraction of useful insights.
cytomapper: a shiny application for hierarchical gating and visualization of multiplex imagesThe cytomapper package, designed for processing multiplex images, includes a
shiny application that facilitates the hierarchical gating of cells using
specific markers and allows for the visualization of selected cells. The
graphical user interface (GUI) of this shiny application is designed to assist in
the process of cell labeling. Furthermore, the data from the selected cells can
be saved as a SingleCellExperiment, thereby enabling various downstream
processing methods (Nils Eling, Nicolas Damond, Tobias Hoch 2020; Eling et al. 2020). The cytomapper package offers
comparable functionality for feature extraction as described in the beginning,
providing an algorithm for extracting morphological and intensity
features from multiplex images (Nils Eling, Nicolas Damond, Tobias Hoch 2020).
colocr: interactive ROI selection in image analysis through shiny appThe colocr package, which facilitates the exploration of fluorescent
microscopic images, features a GUI accessible through a shiny app. This GUI
can be invoked locally or accessed online. The process of image analysis
frequently necessitates the input of manual labor, particularly in the selection
of ROIs. This package streamlines the process of selecting ROIs by
semi-automating it, thereby allowing users to review and interactively select
one or more ROIs. Moreover, the app offers the option to interactively adjust
parameters such as threshold, tolerance, denoising, and hole filling, thereby
enhancing user control and precision in image analysis by providing immediate
feedback (Ahmed et al. 2019; Ahmed 2020).26
Figure 11: Shiny Application of the colocr Package: The figure depicts an interactive image analysis graphical user interface (GUI), invoked locally from the RStudio integrated development environment (IDE). It comprises multiple sliders for real-time parameter adjustments and supports the selection of multiple distinct regions of interest (ROIs). Users can interactively select ROIs and extract characteristics such as pixel intensity. Furthermore, the tool offers functionalities to compute co-localization, providing comprehensive analysis capabilities. Available at: https://mahshaaban.shinyapps.io/colocr_app2/ or run: colocr::colocr_app().
magick: shiny and Tcl/Tk tools for interactive image explorationA basic demo version of an interactive web interface for the magick R package
is available via a shiny app. While it remains a demonstration version and
does not encompass all the functionalities of the full package, it is not
suitable for in-depth analysis of large-scale imaging data. In contrast, the app
provides fundamental tools for image processing, including blurring, imploding,
rotating, and more. This tool is designed to facilitate basic image
processing tasks in an interactive
environment.27
Additionally, a distinct package is available that provides the functionality of
magick in an interactive manner. This package, called magickGUI, was
developed by Ochi (2023). The interactive features are based on the Tcl/Tk
wrapper for R and include functions for thresholding, edge detection, noise
reduction, and many more.
biopixR: interactive Tcl/Tk function for feature extractionIn the biopixR package, the tcltk package — which enables Tcl/Tk integration
in R — was employed to create an interactive function. This function initiates
the launch of a GUI that streamlines the process of feature extraction by
facilitating object detection and enabling users to select between edge
detection and thresholding for segmentation. The GUI displays the currently
detected edges (when using edge detector) or all detected coordinates (when
using threshold) and the object centers within an image. The application
includes sliders that allow users to adjust parameters and magnify the image.
This interactive function is designed to facilitate the parameter selection
process, as the chosen parameters affect the quality of image segmentation
(Brauckhoff et al. 2024).
R packages for image processingIn contrast to the previously mentioned general-purpose tools, some packages have been designed with a specific focus on particular research areas. These specialized tools address the unique challenges encountered in those fields and offer versatile solutions for analyzing the data collected in those domains. While a complete survey of the available packages is outside the scope of this article, a concise overview of the most pertinent packages and their applications will be presented.
fslr: analysis of neuroimage dataThe fslr package serves as a wrapper for the FSL software, enabling the use
of the ‘FMRIB’ Software Library within the R environment. The
FSL software is a widely utilized tool for the analysis and processing of
neuroimaging data, including MRI. The package employs the use of NIfTI images
to facilitate the execution of processing tasks, thereby introducing
capabilities such as brain extraction and tissue segmentation, which were
previously unavailable in R (Muschelli et al. 2015; Muschelli 2022).
colocr: co-localization analysis of fluorescence microscopy imagesA common application derived from fluorescence microscopy, which is extensively utilized in biological research, is co-localization analysis. This analysis assesses the distribution of signals across different color channels to determine whether the positioning of objects is correlated (Dunn et al. 2011; Ahmed et al. 2019). The objective of this software is to streamline the analysis process by providing tools for loading images, selecting regions of interest, and calculating co-localization statistics (Ahmed et al. 2019; Ahmed 2020). It incorporates methods outlined by Dunn et al. (2011).28
CRAN offers a list of packages tailored to medical image analysis, accompanied by detailed descriptions of their applications. This list can be accessed via the following URL:
https://cran.r-project.org/web/views/MedicalImaging.html
Moreover, the Bioconductor repository contains a number of packages focused on single-cell analysis, as detailed by Amezquita et al. (2019). The Bioconductor project is an initiative dedicated to the collaborative development and the use of scalable software for computational biology and bioinformatics. Its objective is to reduce the entry barriers to interdisciplinary research and to improve the remote reproducibility of scientific findings (Gentleman et al. 2004). Other packages identified during the course of our research, though not explored in depth, are acknowledged in the forthcoming summary:
| Application | Repo | based on | License | Status | |
|---|---|---|---|---|---|
| adimpro by Polzehl and Tabelow (2007) |
Adaptive Smoothing | CRAN | Image Magick | GPL (\(\geq\) 2) |
*2006-10-27 °2023-09-06 |
| phenopix by Filippa et al. (2016) |
Vegetation phenology | CRAN | jpeg | GPL-2 | *2017-06-16 °2024-01-19 |
| gitter by Wagih and Parts (2014) |
Pinned Microbial Cultures | CRAN-archived | EBImage | LGPL | *2013-06-29 †2020-01-16 |
| TCIApathfinder by Russell et al. (2018) |
Cancer Imaging | CRAN | Rnifti | MIT | *2017-08-20 °2019-09-21 |
| SPUTNIK by Inglese et al. (2018) |
Mass Spectrometry Imaging | CRAN | imager | GPL (\(\geq\) 3) |
*2018-02-19 °2024-04-16 |
| SAFARI by Fernández et al. (2022) |
Shape analysis | CRAN | EBImage | GPL (\(\geq\) 3) |
*2021-02-25 |
| pavo by Maia et al. (2019) |
Spectral and Spatial analysis | CRAN | magick & imager | GPL (\(\geq\) 2) |
*2012-12-05 °2023-09-24 |
| miet by Combès (2020) |
Magnetic Resonance images | gitlab | Rnifti | MIT | *2019-09-06 °2023-12-20 |
| scalpel by Petersen et al. (2017) |
Calcium imaging | CRAN | - | GPL (\(\geq\) 2) |
*2017-03-14 °2021-02-03 |
| ProFit by Robotham et al. (2016) |
Galaxy images | CRAN-archived | EBImage | LGPL-3 | *2016-09-29 †2022-08-08 |
| fsbrain by Schäfer and Ecker (2020) Schaefer (2024) |
Neuroimaging | CRAN | magick | MIT | *2019-10-30 °2024-02-03 |
| geomorph by Adams and Otárola‐Castillo (2013) |
Geometric morphometric shape analysis | CRAN | jpeg | GPL (\(\geq\) 3) |
*2012-10-26 °2024-03-05 |
| imbibe | Medical images | CRAN | Rnifti | BSD-3-clause | *2020-10-26 °2022-11-09 |
| opencv by Ooms and Wijffels (2024) |
edge, body, face detection | CRAN | OpenCV | MIT | *2019-04-01 °2023-10-29 |
| DRIP | jump regression, denoising, deblurring | CRAN | - | GPL (\(\geq\) 2) |
*2015-09-22 °2024-02-05 |
| imagefluency by Mayer (2024) |
image statistics based on fluency theory | CRAN | magick & OpenImageR | GPL-3 | *2019-09-27 °2024-02-22 |
| mand by Kawaguchi (2021) |
Neuroimaging | CRAN | imager | GPL-2 GPL-3 |
*2020-05-06 °2023-09-12 |
| recolorize by Weller et al. (2024) |
Segmentation | CRAN | imager | CC BY 4.0 | *2021-12-07 |
| MaxContrastProjection by Jan Sauer (2017) |
maximum contrast projection | Bioc | EBImage | Artistic-2.0 | *2017-04-25 †2020-04-28 |
The majority of the aforementioned packages are designed to encompass all facets
of image analysis, including preprocessing, quantification, and visualization.
This integration is typically achieved through the utilization of one or more
general-purpose packages (Table 1 and 2).
The combination of existing packages or libraries with new code facilitates the
development of specialized packages. R, as a package-based language, provides a
convenient means of combining these specialized packages to meet the specific
needs of the individual user. The following section illustrates the combination of
packages to perform statistical analysis on quantified image data.
biopixR and countfitteR: quantitative analysis of DNA double strand breaksDNA double strand breaks (DSBs) represent a particularly severe form of DNA damage, frequently resulting in apoptotic cell death in the absence of repair. The extent of DNA damage can be quantified through immunofluorescence staining, which employs antibodies against the phosphorylated histone protein H2AX (\(\gamma\)H2AX). The staining process results in the formation of \(\gamma\)H2AX foci, which serve as a quantitative representation of the number of DNA DSBs. It has been proposed that the number of DNA DSBs is indicative of the efficacy of an anti-tumor agent, thereby enabling the assessment of individual patient responses to therapies and the evaluation of the general cytotoxic effects of treatments in vivo. This enables more precise modulation of therapy according to the patient’s individual needs (Rödiger et al. 2018; Schneider et al. 2019; Ruhe et al. 2019).
In the following example, the biopixR package was employed to quantify DNA
double-strand breaks, resulting in an output of foci per cell (Figure
12). To achieve this objective, the green fluorescent foci were
extracted by applying the objectDetection() function to the green color
channel of the image (Figure 12A). The result of the foci extraction
is illustrated in Figure 12B using the changePixelColor() function,
whereby each of the distinct foci is highlighted in a different color. The DAPI-stained
nuclei were extracted through the application of thresholding on the blue color
channel. Subsequently, the resulting data frame was subjected to size filtering
in order to eliminate any detected noise. The final quantification of foci per
cell was achieved by comparing the coordinates of nuclei and foci in the
obtained data frames. This result can then be further analyzed using the
countfitteR package, which provides an automated evaluation of
distribution models for count data (Burdukiewicz 2019; Chilimoniuk et al. 2021). The
resulting distribution is presented in Figure 13.
# Load the 'biopixR' package
library(biopixR)
# Import image from specified path
DSB_img <- importImage("figures/tim_242602_c_s3c1+2+3m4.tif")
# Extract the blue color channel representing the nuclei and
# the green color channel representing yH2AX foci
core <- as.cimg(DSB_img[, , , 3])
yH2AX <- as.cimg(DSB_img[, , , 2])
# Process the nuclei: thresholding, labeling, and converting to a data frame
cores <-
threshold(core) |> label() |> as.data.frame() |> subset(value > 0)
# Calculate the center and size for the nuclei
DT <- as.data.table(cores)
cores_center <-
DT[, list(mx = mean(x),
my = mean(y),
size = length(x)), by = value]
# Filter the nuclei based on size, to discard noise
cores_clean <-
sizeFilter(cores_center,
cores,
lowerlimit = 150,
upperlimit = Inf)
# Detect objects yH2AX foci in green color channel
DSB <- objectDetection(yH2AX, alpha = 1.1, sigma = 0)
# Function to compare coordinates from two data frames and count matches
compareCoordinates <- function(df1, df2) {
# Create a single identifier for each coordinate pair
df1$coord_id <- paste(round(df1$mx), round(df1$my), sep = ",")
df2$coord_id <- paste(df2$x, df2$y, sep = ",")
# Find matches by checking if coordinates from df2 exist in df1
matches <- df2$coord_id %in% df1$coord_id
# Convert df2 to a data table and add a column indicating matches
DT <- data.table(df2)
DT$DSB <- matches
# Summarize the results
result <-
DT[, list(count = length(which(DSB == TRUE))), by = value]
return(result)
}
# Compare coordinates between detected DSB centers and cleaned nuclei coordinates
count <- compareCoordinates(DSB$centers, cores_clean$coordinates)
# Extract the count column for further analysis
to_analyze <- count[, 2]
Figure 12: Quantification of DNA Double Strand Breaks: A) The image displays cells with nuclei stained using DAPI. The quantitative marker for DNA double strand breaks, \(\gamma\)H2AX, targeted with a specific antibody, is visible as green fluorescent foci. The experimental procedure follows the method described by Rödiger et al. (2018). B) The \(\gamma\)H2AX foci are quantified using the biopixR package. The detected foci are highlighted in different colors using the changePixelColor() function.
Figure 13: Analyzing Count Data with the countfitteR Package: The data representing the number of foci per cell obtained from the biopixR analysis were imported into the interactive shiny interface of the countfitteR package. This package analyzed the distribution and summarized the results. One outcome is illustrated in this figure, which shows the frequency distribution of a specific count of foci per cell.
RZ-stack imaging refers to the capture of images that possess a third dimension, specifically image depth, which enables the spatial capture of molecules or the reconstruction of the three-dimensional architecture of tissues. One method for achieving z-stacking involves capturing multiple two-dimensional images at uniform intervals over the depth of an object by changing the focal plane. The individual 2D images are then reconstructed to create a 3D model (Trivedi and Mills 2020; Kim et al. 2022).
The only packages currently available in the R programming language for
dealing with z-stack imaging are spatialTIME and MaxContrastProjection.
However, the spatialTIME package necessitates preprocessing and is therefore
unable to handle the images directly (Creed et al. 2021). The other package,
MaxContrastProjection, has unfortunately been removed from Bioconductor. The
package is capable of performing maximum contrast projection, whereby the
z-stacks of a 3D image are merged into a 2D image (Jan Sauer 2017). To
the best of our knowledge, these are the only packages in R that address the
topic of z-stack imaging.
The exponential growth of data, which reached levels of zettabytes (\(10^{21}\) bytes) as early as 2012 (Sagiroglu and Sinanc 2013), is accompanied by a significant increase in image generation due to advancements in imaging technologies such as microscopy. High-resolution images produced in a single experiment can result in data sets exceeding terabytes (Peng et al. 2012; Eliceiri et al. 2012). This surge in data generation across various fields has initiated the era of Big Data, which presents considerable challenges in the handling and interpretation of massive data sets (Cui et al. 2015). In automated microscopy, the rapid acquisition of large image volumes facilitates extensive screening processes but complicates the conversion of image stacks into actionable information and discoveries, resulting in a critical need for analytical pipelines that can efficiently identify regions of interest, compute relevant features, and perform statistical analysis, ensuring reproducibility and reliability (Wollman and Stuurman 2007).
The extraction of quantitative information from images is a common practice, but it is becoming increasingly complex and error-prone when performed manually. This complexity requires the implementation of high-throughput methods capable of autonomously processing multiple images (Olivoto 2022). These developments are crucial not only in specialized fields such as immunohistochemistry, fluorescence in situ hybridization (Ollion et al. 2013), drug discovery, and cell biology (Shariff et al. 2010), but also in promoting a data-driven approach to biological research, thereby accelerating tasks and enhancing research productivity (Rittscher 2010).
The R programming language has limitations in handling large data sets. Since
R places temporary copies of data in the random access memory (RAM) to access
objects, it can lead to memory overload when processing data sets that exceed
the available RAM. Additionally, R uses RAM to store generated data, so large
lists of imported images can easily overwhelm the RAM. Moreover, R typically
executes code on a single thread, not utilizing the full capabilities of the
central processing unit (CPU). Several packages address issues such as
file-based access and parallel computing, thereby enhancing R‘s capability to
handle big data. One approach is to combine R with the ’Hadoop’ library
(Prajapati 2013; Oussous et al. 2018). Another effective method for managing big data
is the use of the HDF5, which efficiently manages
data storage and access, provides multicore reading and writing, and is
well-suited for organizing complex data collections. The cytomapper package
utilizes HDF5 to optimize file management (Koranne 2011; Folk et al. 2011; Nils Eling, Nicolas Damond, Tobias Hoch 2020).
Other packages, such as pliman, biopixR, and FIELDimageR, include features
for optimized batch processing, such as parallel processing, by utilizing the
foreach package for multi-core processing (Matias et al. 2020; Olivoto 2022; Brauckhoff et al. 2024). However, these packages are not fully optimized for big data. The
biopixR package simplifies image processing by providing a pipeline that scans
entire directories and verifies image uniqueness using Message Digest 5 (MD5)
sums. It enables the application of specific filters to batches of images and
generates an RMarkdown log file detailing the operations performed. The results
are saved in a manageable CSV format, enhancing the
efficiency of handling whole image directories (Brauckhoff et al. 2024).
In conclusion, while R offers a range of options for handling big data, these
options are not widely implemented in image processing packages. Consequently,
the optimization and creation of workflows capable of handling big data is left
to the end-user.
In conclusion, we present a summary of the major R packages previously
discussed. This summary provides an overview of the general applications,
published repositories, and licensing information associated with these
packages. Furthermore, it includes a list of the dependencies or libraries that
these packages rely on. The status column indicates both the initial publication
date and the date of the most recent update, thereby demonstrating the ongoing
commitment to maintaining these packages (Table 2).
| Application | Repo | based on | License | Status | |
|---|---|---|---|---|---|
| imager by Barthelmé and Tschumperlé (2019) |
general purpose | CRAN | Cimg | LGPL-3 | *2015-08-26 °2024-04-26 |
| magick by Ooms (2024b) |
general purpose | CRAN | Image Magick | MIT | *2016-07-24 °2024-02-18 |
| EBImage by Pau et al. (2010) |
general purpose | Bioc | - | LGPL | *2006-04-27 °2024-05-01 |
| biopixR by Brauckhoff et al. (2024) |
bioimages | CRAN | imager & magick | LGPL (\(\geq\) 3) |
*2024-03-25 °2024-11-11 |
| pliman by Olivoto (2022) |
plant images | CRAN | EBImage | GPL (\(\geq\) 3) |
*2021-05-15 °2023-10-14 |
| mxnorm by Harris et al. (2022b) |
multiplex images | CRAN | - | MIT | *2022-02-22 °2023-05-01 |
| DIMPLE by Masotti et al. (2023) |
multiplex images | GitHub | - | MIT | *2023-09-07 |
| cytomapper by Eling et al. (2020) |
multiplex images | Bioc | EBImage | GPL (\(\geq\) 2) |
*2020-10-28 °2024-05-01 |
| SPIAT by Yang et al. (2020) |
spatial data | Bioc | Spatial Experiment | Artistic-2.0 | *2022-11-02 °2024-05-01 |
| spatialTIME by Creed et al. (2021) |
spatial data | CRAN | - | MIT | *2021-05-14 °2024-03-11 |
| celltrackR by Wortel et al. (2021) |
motion analysis | CRAN | - | GPL-2 | *2020-03-31 °2024-03-26 |
| FIELDimageR by Matias et al. (2020) |
agricultural field trails | GitHub | EBImage | GPL-3 | *2019-11-01 °2024-05-03 |
| fslr by Muschelli et al. (2015) |
MRI of the brain | CRAN | FMRIB library | GPL-3 | *2014-06-13 °2022-08-25 |
| colocr by Ahmed et al. (2019) |
fluorescence microscopy | CRAN | imager & magick | GPL-3 | *2019-05-31 °2020-05-08 |
| imageseg by Niedballa et al. (2022a) |
image segmentation | CRAN | magick | MIT | *2021-12-09 °2022-05-29 |
| SimpleITK by Beare et al. (2018) |
general purpose | GitHub | Simple ITK | Apache 2.0 | *2015-11-16 °2020-09-17 |
| pixelclasser by Real (2024) |
image segmentation | CRAN | jpeg & tiff | GPL-3 | *2021-10-21 °2023-10-18 |
| OpenImageR | general purpose | CRAN | Rcpp | GPL-3 | *2016-07-09 °2023-07-08 |
| RniftyReg | image registration | CRAN | Rcpp & Rnifti | GPL-2 | *2010-09-06 °2023-07-18 |
The packages outlined in Table 2 are examined in terms of
their individual dependencies. A minimal number of dependencies is essential for
ensuring long-term stability and functionality. The packages are organized
according to their dependencies and imports, which were extracted from the
DESCRIPTION files to facilitate the identification of similarities between the
packages. The relationships between the packages are illustrated in the form of
a dendrogram (Figure 14).
Figure 14: Dendrogram of Hierarchically Clustered Package Dependencies: The dendrogram depicts the outcomes of a hierarchical clustering of various image analysis packages, based on their named dependencies and imports, as extracted from their respective DESCRIPTION files. Each branch represents a distinct package, and the proximity between branches reflects the degree of similarity in their dependencies and imports. The required distance matrix was calculated using the binary method, also known as Jaccard distance. To perform the hierarchical clustering, the complete linkage clustering method was employed (R Core Team 2023).
The Tables 1 and 2 highlight an array of R
packages employed within bioimage informatics. These tools cater to diverse
applications such as adaptive smoothing, vegetation phenology analysis,
microbial culture imaging, cancer imaging, mass spectrometry imaging, shape
analysis, spectral and spatial analysis, magnetic resonance image processing,
calcium imaging, galaxy image analysis, neuroimaging, geometric morphometric
shape analysis, medical image processing, edge detection, body and face
recognition, jump regression, denoising, and deblurring.
Many of these packages rely on common image processing libraries such as
‘ImageMagick’ and ‘CImg’ or specialized libraries like ‘RNifti’ for neuroimaging
data and OpenCV for computer vision tasks. Some notable examples include
adimpro, gitter, SAFARI, pavo, rental, scalpel, ProFit, and fsbrain.
The majority of these packages are hosted on CRAN, which serves as the primary
repository for R packages. Notably, one package, rental, is hosted on GitLab,
indicating that some packages may also be developed and distributed through
alternative platforms. R is an open-source, free, and cross-platform
programming language that extends these values to its packages
(R Core Team 2023). The CRAN Repository Policy states that package authors
“should make all reasonable efforts to provide cross-platform portable code,”
typically requiring packages to run on at least two major R
platforms.29 Similarly,
the standard tests employed by Bioconductor encompass evaluations on all major
platforms, including Linux, macOS, and
Windows.30
Thus, it can be concluded that the majority of packages in these repositories
are compatible across multiple platforms.
The most commonly used license in this domain is the GNU General Public License
(GPL), particularly versions 2 and 3. Other licenses employed include the Lesser
GNU General Public License (LGPL), MIT, Apache License 2.0, and others. The
prevalence of open-source licenses reflects the collaborative nature of R
package development. It’s essential to ensure compatibility when combining code
from different packages with varying licenses; otherwise, legal considerations
might arise.
As previously outlined, the most fundamental image processing packages in R are
imager, magick, EBImage, OpenImageR, and SimpleITK. Primarily,
imager, magick, and EBImage form the foundation for the majority of the
specialized packages reviewed. These packages support various formats, with JPEG
and PNG being the most common and supported by all five packages. BMP and TIFF
are also widely supported, while PDF and SVG formats are exclusively supported
by magick.
imager |
magick |
EBImage |
OpenImageR |
SimpleITK |
|
|---|---|---|---|---|---|
| JPEG | + | + | + | + | + |
| PNG | + | + | + | + | + |
| BMP | + | + | - | - | + |
| TIFF | - | + | + | + | + |
| - | + | - | - | - | |
| SVG | - | + | - | - | - |
The ongoing development of new code by the R community
significantly enhances the capabilities of image analysis, fostering both growth
and adaptability within the community. This ensures that R remains
well-equipped to address emerging challenges effectively. The result is a
diverse range of image processing packages, including versatile general-purpose
tools and specialized pipelines designed for intricate analyses of biological
images. This extensive array of tools in R not only demonstrates the versatility
and applicability of these packages across different scientific disciplines but
also solidifies R’s position as an invaluable resource for researchers
interested in leveraging image analysis to uncover novel insights. This review
provides a concise overview of the current landscape of image processing
packages available in R, emphasizing the pivotal role these tools play in
advancing scientific research and discovery. The comprehensive toolkit, R,
empowers researchers to drive forward innovations and enrich the scientific
community. Finally, it is noteworthy that 92% of the 38 discovered packages are
active in their respective repositories and thus considered up to date.
Furthermore, 66% of these packages have been actively maintained with updates
in the past 1.5 years. Among the identified packages, 14 provide users with GUIs
or interactive functions. These packages include: FIELDimageR, cytomapper,
colocr, biopixR, EBImage, magick, imager, pavo, pliman,
imagefluency, geomorph, fsbrain, scalpel, and adimpro. The majority of
the 38 packages identified during the research can be considered autonomous,
offering all the necessary features for extensive image data analysis,
including image import, processing, and visualization. However, some packages
related to multiplex imaging necessitate preprocessing, rendering them unable to
provide a complete analysis within the R environment.
All mentioned packages are open source and available either on CRAN, Bioconductor or GitHub.
Predicting the future is challenging, yet here we provide some opinions on
trends in bioimage informatics, which ultimately will also be seen in R.
Publications and conferences in the fields of image processing and computer
vision show that advances are driven by artificial intelligence (AI), deep
learning (particularly Convolutional Neural Networks (CNNs), Large Language
Models (LLMs), and Vision Transformer models (VTs)), and data visualization
(Rabbani et al. 2021; Hameed et al. 2021; Velden et al. 2022; Belcher et al. 2023; Ye et al. 2024).
One example of deep learning is imageseg, which is using a CNN (U-Net and U-Net++
architectures) for general purpose image segmentation (Niedballa et al. 2022b). Another
development is the deeper integration of R with advanced deep learning
frameworks, which will enable users to build and deploy models, with
applications like image classification, segmentation, and object detection. An example of
such integration is ellmer, which makes various LLMs accessible from R for
output streaming, tool calling, and structured data extraction.
The question arises: Is AI merely a buzzword, or is it here to stay? Given that
AI is grounded in science and we already see applications in R,
the latter is more probable. Consequently, R
bioimage packages will be developed that combine image data with other
multimodal data types, such as text and sensor data. Generative AI and advanced
visualization techniques are also one topic due to the availability of
generative models like diffusion models and Generative Adversarial Networks
(GANs). These technologies open new possibilities for image augmentation and
enhanced data visualization. It is important that such technologies stick to
one of R’s strengths, which is explainability, in particular focusing on transparent,
understandable, and explainable AI (xAI).
This review was partially funded by the project Rubin: NeuroMiR (03RU1U051A, federal ministry of education and research, Germany).
The authors declare no conflict of interest.
We would like to express our gratitude to Dr. Coline Kieffer for providing the microbead images used in this review. We thank Robert M Flight at codeberg.org for reading and improving the manuscript.
Supplementary materials are available in addition to this article. It can be downloaded at RJ-2025-030.zip
https://ngff.openmicroscopy.org/about/index.html, accessed 07/13/2025↩︎
https://cran.r-project.org/, accessed 04/17/2025↩︎
https://github.com/, accessed 04/17/2025↩︎
https://ropensci.r-universe.dev/builds, accessed 04/17/2025↩︎
https://www.bioconductor.org/, accessed 04/17/2025↩︎
https://tiagoolivoto.github.io/pliman/index.html, accessed 07/11/2024↩︎
https://github.com/OpenDroneMap/FIELDimageR, accessed 05/07/2024↩︎
https://github.com/ropensci/pixelclasser, accessed 07/11/2024↩︎
https://cloud.r-project.org/web/packages/pixelclasser/vignettes/pixelclasser.html, accessed 07/11/2024↩︎
https://github.com/jonclayden/RNiftyReg, accessed 07/11/2024↩︎
https://github.com/asgr/imager, accessed 07/11/2024↩︎
https://asgr.github.io/imager/, accessed 07/11/2024↩︎
https://imagemagick.org/script/magick++.php, accessed 07/11/2024↩︎
https://www.imagemagick.org/Magick++/ImageDesign.html, accessed 07/11/2024↩︎
https://georgestagg.github.io/shinymagick/, accessed 07/11/2024↩︎
https://imagemagick.org/, accessed 07/11/2024↩︎
https://github.com/mlampros/OpenImageR, accessed 07/11/2024↩︎
https://mlampros.github.io/OpenImageR/index.html, accessed 07/11/2024↩︎
https://github.com/InsightSoftwareConsortium/SimpleITK-Notebooks, accessed 07/11/2024↩︎
https://github.com/SimpleITK/SimpleITKRInstaller, accessed 07/11/2024↩︎
https://github.com/nateosher/DIMPLE, accessed 07/11/2024↩︎
https://github.com/TrigosTeam/SPIAT-shiny, accessed 07/11/2024↩︎
https://web.archive.org/web/20250125194642/https://www.akoyabio.com/wp-content/uploads/2021/11/Vectra_Polaris_Product_Note_with_MOTiF_Akoya.pdf, accessed 07/14/2025↩︎
https://fridleylab.shinyapps.io/iTIME/, accessed 07/11/2024↩︎
https://github.com/ingewortel/celltrackR, accessed 07/11/2024↩︎
https://mahshaaban.shinyapps.io/colocr_app2/, accessed 07/11/2024↩︎
https://github.com/jeroen/shinymagick, accessed 07/11/2024↩︎
https://github.com/ropensci/colocr, accessed 07/11/2024↩︎
https://cran.r-project.org/web/packages/policies.html, accessed 06/10/2024↩︎
https://contributions.bioconductor.org/bioconductor-package-submissions.html, accessed 06/10/2024↩︎
Text and figures are licensed under Creative Commons Attribution CC BY 4.0. The figures that have been reused from other sources don't fall under this license and can be recognized by a note in their caption: "Figure from ...".
For attribution, please cite this work as
Brauckhoff, et al., "The R Journal: Exploring Image Analysis in R: Applications and Advancements", The R Journal, 2025
BibTeX citation
@article{RJ-2025-030,
author = {Brauckhoff, Tim and Rublack, Julius and Rödiger, Stefan},
title = {The R Journal: Exploring Image Analysis in R: Applications and Advancements},
journal = {The R Journal},
year = {2025},
note = {https://doi.org/10.32614/RJ-2025-030},
doi = {10.32614/RJ-2025-030},
volume = {17},
issue = {3},
issn = {2073-4859},
pages = {212-260}
}